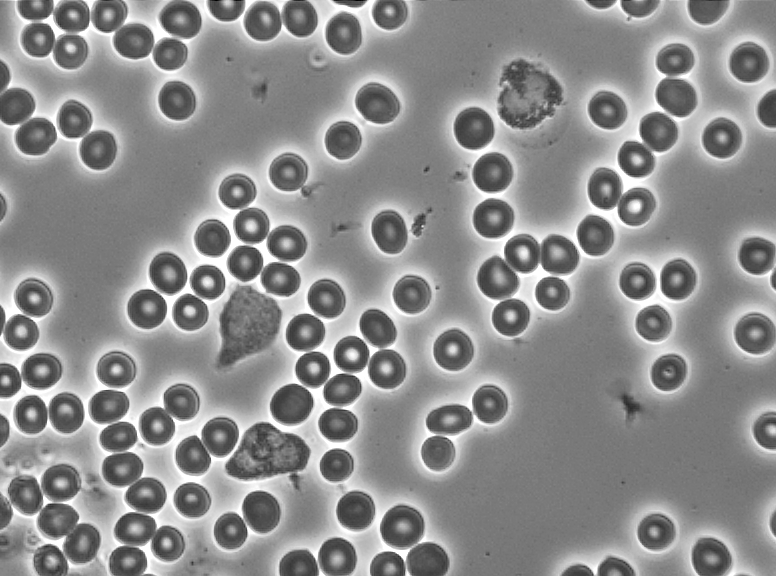

Komplett mikroskop med videokamera säljes
Utmärkt för dig som vill arbeta med levande blodanalys och samtidigt visa din blod live.
Kan även användas till Oxidativ Stress Analys i ljusfält (OSA).
Jag har huvudsakligen använt mikroskopet vid resor och det ryms i handbagaget på flyget.
Säljes med tillhörande digital videokamera, som ger mycket bra bildöverföring till dator med bra inställningsmöjligheter och skärpa.
Kameran passar även utmärkt till mörfältmikroskopering om du vill använda den till ett annat mikroskop. Den ansluts via ethernetuttaget till dator, alternativt via konverteringsadapter USB 3/Ethernets, samt via en transformator till vägguttaget för strömförsörjning.
Mikroskopet ansluts direkt till vägguttaget utan mellanliggande transformator.
Mikroskopuppgifter:
Märke Zeiss, okänt modellnamn och tillverkningsår (minst 15 år gammalt)
Objektiv:
40PL 0,70 160/0,17
Ph2 40/0,65
Plan 2,5/0,08 160/-
Ingen olja behövs för tydlig bild
Reglerbara okular Zeizz CPL W 10 x
Lampa: OSRAM Halostar Starlite 10 w 145 lm (lätta att få tag på till lågt pris)
Vikt 6,2 kg
Höjd ca 40 cm
Bredd ca 18 cm
Emballage saknas
Kamerauppgifter:
Kappa Zelos 41 5c ½” CCD-färgkamera, livebild i 50 Hz vid 823x592 BP total, C-Rom KCC
Zelos POE-nätdel 12 v inklusive GigE nätverkskabel
Zelos Anslutningskabel 12.pol RJ45 (POE)
Inköpt 2014 och renoverad hos Kappa i Tyskland 2024.
Sparsamt använd, då jag huvudsakligen använt den under resor.
Pris:
Komplett med mikroskop, kamera och kablage: 8750 kr inkl. moms 25 %.
Kontakta mig på madeleinemarcus@outlook.com för mer information eller visning.
Mikroskopet finns att prova eller köpa i Tyresö, Stockholm.
Sidan är uppdaterad 250928